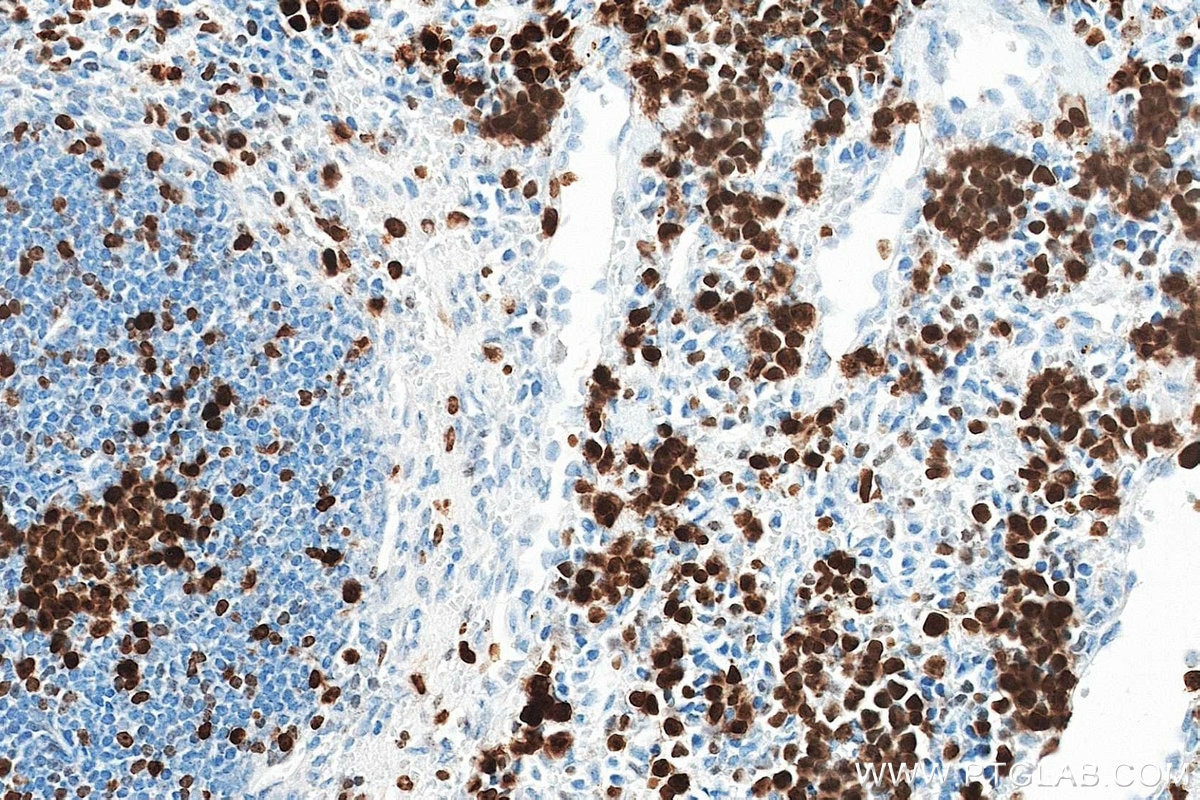
Immunohistochemistry (IHC) staining of mouse spleen tissue using Ki-67 Recombinant monoclonal antibody (84432-1-RR)

Tested Applications
| Positive WB detected in | NIH/3T3 cells |
| Positive IHC detected in | mouse spleen tissue, rat spleen tissue Note: suggested antigen retrieval with TE buffer pH 9.0; (*) Alternatively, antigen retrieval may be performed with citrate buffer pH 6.0 |
| Positive IF/ICC detected in | C2C12 cells, NIH/3T3 cells |
Recommended dilution
| Application | Dilution |
|---|---|
| Western Blot (WB) | WB : 1:1000-1:6000 |
| Immunohistochemistry (IHC) | IHC : 1:1000-1:4000 |
| Immunofluorescence (IF)/ICC | IF/ICC : 1:200-1:800 |
| It is recommended that this reagent should be titrated in each testing system to obtain optimal results. | |
| Sample-dependent, Check data in validation data gallery. | |
Published Applications
| WB | See 1 publications below |
| IHC | See 1 publications below |
| IF | See 1 publications below |
Product Information
84432-1-RR targets Ki-67 in WB, IHC, IF/ICC, ELISA applications and shows reactivity with mouse, rat samples.
| Tested Reactivity | mouse, rat |
| Cited Reactivity | mouse |
| Host / Isotype | Rabbit / IgG |
| Class | Recombinant |
| Type | Antibody |
| Immunogen |
CatNo: Eg1548 Product name: Recombinant Mouse Ki-67 protein (N-rFc) Source: mammalian cells-derived, pHZ-KIsec-N-rFc Tag: N-rFc Domain: 1816-2163 aa of NM_001081117.2 Sequence: DETTKIALQSPQPGHIINPASMKRQSNMSLRKDMREFSILEKQTQSRGRDAGTPAPMQEENGTTAIMETPKQKLDFIGNSTGHKRRPRTPKNRAQPLEDLDGFQELFQTPAGASDPVSVEESAKISLASSQAEPVRTPASTKRRSKTGLSKVDVRQEPSTLGKRMKSLGRAPGTPAPVQEENDSTAFMETPKQKLDFTGNSSGHKRRPQTPKIRAQPLEDLDGFQELFQTPAGANDSVTVEESVKMSLESSQAEPVKTPASTKRLSKTGLSKVDVREDPSILEKKTKSPGTPAPVQEENDCTAFMETPKQKLDFTGNSSGHKRRPRTPKIRAQPLEDLDGFQELFQTP Predict reactive species |
| Full Name | antigen identified by monoclonal antibody Ki 67 |
| Calculated Molecular Weight | 351kDa |
| Observed Molecular Weight | 350 kDa |
| GenBank Accession Number | NM_001081117.2 |
| Gene Symbol | ki67 |
| Gene ID (NCBI) | 17345 |
| RRID | AB_3671959 |
| Conjugate | Unconjugated |
| Form | Liquid |
| Purification Method | Protein A purification |
| UNIPROT ID | E9PVX6-1 |
| Storage Buffer | PBS with 0.02% sodium azide and 50% glycerol, pH 7.3. |
| Storage Conditions | Store at -20°C. Stable for one year after shipment. Aliquoting is unnecessary for -20oC storage. 20ul sizes contain 0.1% BSA. |
Background Information
The Ki-67 protein (also known as MKI67) is a cellular marker for proliferation. Ki67 is present during all active phases of the cell cycle (G1, S, G2 and M), but is absent in resting cells (G0). Cellular content of Ki-67 protein markedly increases during cell progression through S phase of the cell cycle. Therefore, the nuclear expression of Ki67 can be evaluated to assess tumor proliferation by immunohistochemistry.
Protocols
| Product Specific Protocols | |
|---|---|
| IF protocol for Ki-67 antibody 84432-1-RR | Download protocol |
| IHC protocol for Ki-67 antibody 84432-1-RR | Download protocol |
| WB protocol for Ki-67 antibody 84432-1-RR | Download protocol |
| Standard Protocols | |
|---|---|
| Click here to view our Standard Protocols |
Publications
| Species | Application | Title |
|---|---|---|
Mater Today Bio A smart CO-releasing MnSiO3-based hydrogel enhances diabetic wound healing through NIR-triggered antibacterial, anti-inflammatory, and pro-regenerative mechanisms | ||
Life Sci Fecal microbiota transplantation promotes hair growth through gut microbiome and metabolic regulation | ||
J Gastrointest Oncol The highly expressed GOLPH3 in colorectal cancer cells activates smoothened to drive glycolysis and promote cancer cell growth and radiotherapy resistance | ||
Small IL-21 Loading CaMnCO3 Vitality Backpacks Boost CAR-T Cell Synergistic Immunotherapy | ||
Int Immunopharmacol SMC4 promotes immune evasion by inhibiting endogenous interferon signaling and upregulating PD-L1 expression in triple negative breast cancer |